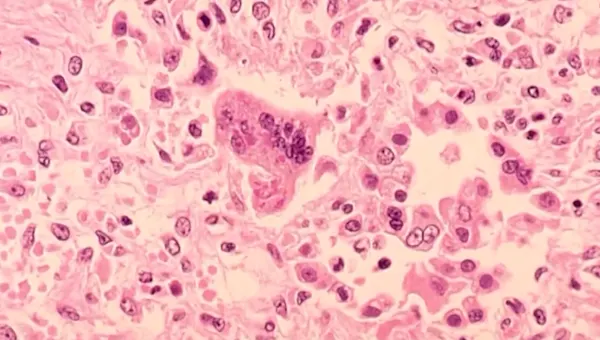

Can Canada’s ‘rockstar banker’ PM take on Trump and win? – podcast | Canada

Just a few months ago, Canada's future was clearly visible – conservatives were on the rise. After nearly a decade of power, Justin Trudeau resigned, and his liberal party appeared to be falling. But then came his threat to not only do Donald Trump's tariffs, but Canada would become the “51st state.” The Canadians were […]
health officials warn of potential exposure
A child in Suffolk County tested positive for measles, prompting health officials to sound the alarm about potential exposure to others. The child, under the age of five and unvaccinated, was treated last week at Cohen Children’s Medical Center in New Hyde Park, located on the Nassau-Queens border. Authorities are investigating whether anyone else may […]
NC health insurance provider to stop coverage at end of June, impacting thousands – WITN

RAILY, N.C. (WITN) – Health insurance coverage for thousands of families across our state is in scope after major providers announced they would cease operations at the end of June. The NC League of Dunicitality Health Benefit Trust will end operation on June 30th. It offers government employees and their families health benefits, including medical […]
The Pacers used a football play for NBA’s best game-winner this season

If the NBA season ends today, Milwaukee Bucks The Indiana Pacers faced off in the first round of the 2025 NBA playoffs. If the appetizer on Tuesday night was any indication, basketball fans will be in a great series if it happens. The Pacers surprised the 114-113 Bucks in a central division showdown. There is […]
Phil Mickelson Shows His Support For Elon Musk And His Unbelievable Moves

Fill is rolling! Here in America, and perhaps around the world, Elon Musk has become an incredibly hated person. In his defense, the majority of the negativity comes from the Rooney's left wing, who, for some reason, is crazy about him trying to defeat both government spending and total waste. Elon had to deal with […]
US bans flights to Haiti’s capital until September

UN (AP) – The United Nations (AP) — The United States on Tuesday extended a ban on flights to Haiti's capital until September 8 due to an escalation of gang violence that UN human rights experts in the Caribbean say is more dire than ever. The Federal Aviation Administration announcement extended the ban on US […]
New Winsome Earle-Sears ad accuses top Dem of being soft on illegal immigrant crime

Exclusive: Virginia Governor Winsam Earl Sears released her first ad on Tuesday to face her democratic opponent, former US lawmaker Abigail Spanberger. advertisement They intended to link Spanburger, Culpeper and King George, who previously represented Washington's expenses around Fredericksburg, to an increase in violent crime committed by illegal immigrants in otherwise safe areas. The ad […]
ICE, DEA arrest criminal illegal aliens on idyllic Massachusetts island

New England's U.S. Immigration and Customs Enforcement (ICE) and Drug Enforcement Agency (DEA) agents carried out a joint operation in Nantucket, Massachusetts on Tuesday to arrest “illegal criminals.” In a post on X, the DEA New England division said the agent supported the ice and ice enforcement and removal operations that were arrested on an […]
India Recovers Hundreds of Citizens Enslaved in Scam Centers

Ministry of Foreign Affairs of India announcement On Monday, 283 Indian citizens rescued from enslavement by the Southeast Asia cybercrime ring were brought into their homes from Thailand by the Indian Air Force (IAF). united nations Published An astonishing August 2023 report seduced people in India, China and Indonesia using fake employment ads and enslaved […]
FEMA fires 3 more supervisors tied to home-skipping scandal impacting Trump supporters

The Federal Emergency Management Agency has fired three supervisors, tied to a political bias scandal involving workers who were instructed not to provide disaster relief assistance to Florida homeowners. Cameron Hamilton, acting manager of FEMA, wrote in a letter dated March 4th that the agency had carried out the matter.A thorough investigation“After it was revealed […]